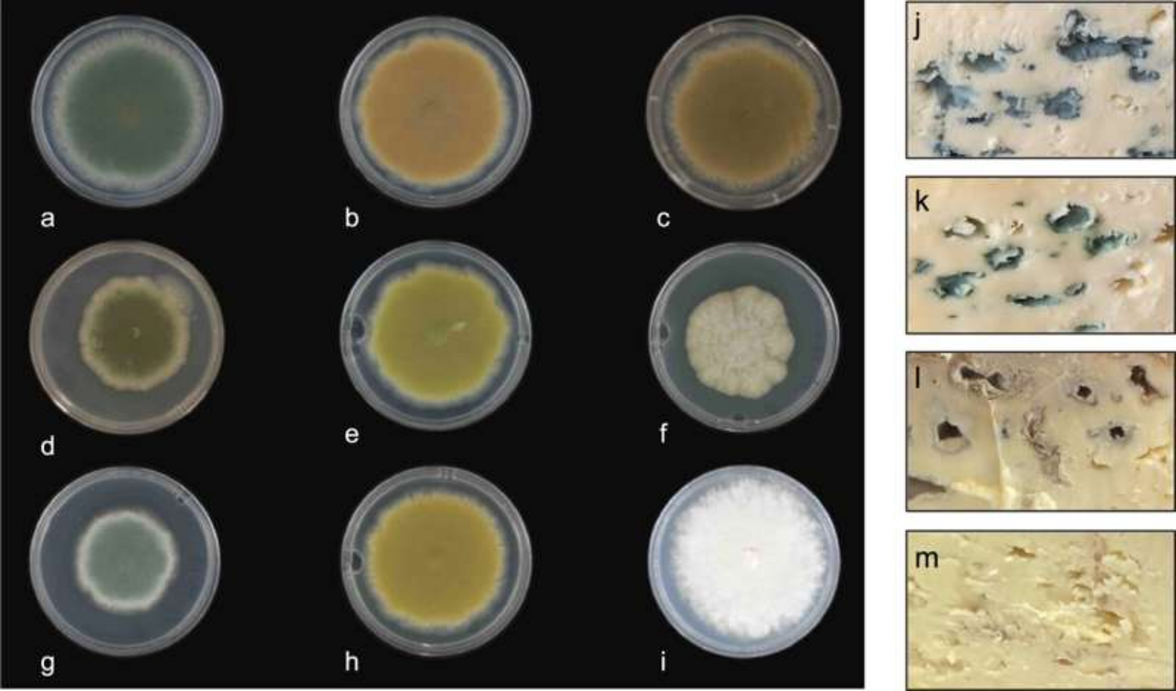

Эксперты из Ноттингемского университета выяснили, как создавать голубой сыр разных оттенков.
Выяснив, как образуются классические сине-зеленые прожилки, группа экспертов смогла создать множество различных грибковых штаммов, которые можно использовать для производства сыра разных цветов - от белого до желто-зеленого, от красно-коричнево-розового до светло- и темно-синего. Результаты исследования опубликованы в журнале npj Science of Food.
Плесень Penicillium roqueforti используется во всем мире для производства сыров с голубыми прожилками, таких как стилтон, рокфор и горгонзола. Их уникальный сине-зеленый цвет и вкус обусловлен пигментированными спорами, образующимися в процессе роста грибка. Используя комбинацию биоинформатики, целевых удалений генов и экспрессии гетерологичных генов, исследовательская группа под руководством Пола Дайера, выяснила, каким образом производится сине-зеленый пигмент.
Исследователи обнаружили, что биохимический процесс постепенно формирует синие пигменты, начиная с белого цвета, который постепенно становится желто-зеленым, красно-коричнево-розовым, темно-коричневым, светло-голубым и, наконец, темно-сине-зеленым. Затем авторы смогли использовать некоторые классические методы, безопасные для пищевых продуктов, чтобы "заблокировать" этот путь в определенных точках, и таким образом создать штаммы с новыми цветами, которые можно использовать в производстве сыра.
Дайер рассказал: "Мы интересуемся сырными грибками уже более 10 лет, и традиционно при производстве сыров с плесенью получаются голубые сыры, такие как стилтон, рокфор и горгонзола, в которых используются фиксированные штаммы грибков, имеющие сине-зеленый цвет. Мы хотели узнать, сможем ли мы разработать новые штаммы с новыми вкусами и внешним видом. "Для этого мы спровоцировали половое размножение грибков, и впервые нам удалось создать широкий спектр штаммов с новыми вкусами, включая привлекательные мягкие и интенсивные. Затем мы создали новые цветовые версии некоторых из этих новых штаммов".
"Мы обнаружили, что вкус этих новых сыров очень похож на оригинальные голубые штаммы", - говорит Дайер. "Были тонкие различия, но не очень значительные. Самое интересное, что после того, как мы сделали сыр, мы провели несколько дегустационных тестов с добровольцами и обнаружили, что когда люди пробовали штаммы светлого цвета, они считали их более мягкими на вкус. В то время как темные сорта имели более насыщенный вкус. Аналогичным образом, когда люди пробовали более красновато-коричневый и светло-зеленый сорта, они считали, что в них есть фруктовые нотки, в то время как по данным лабораторных тестов они были схожи по вкусу. Это показывает, что люди воспринимают вкус не только по тому, что они пробуют, но и по тому, что они видят".
Группа теперь будет работать с сыроделами в Ноттингемшире и Шотландии, чтобы создать новые цветовые варианты голубого сыра. Также уже создана университетская компания Myconeos, которая займется коммерциализацией штаммов. "Лично я думаю, что люди получат действительно приятные ощущения от употребления этих новых сыров и, надеюсь, это привлечет новых потребителей", - добавляет Дайер.
Цветные мутантные штаммы и их применение в производстве сыра. (a-i) Дикий тип и репрезентативные мутантные штаммы Pencillium roqueforti. (j-m) Поперечные срезы сыров, изготовленных с использованием родительских и производных (мутантов) штамма Penicillium roqueforti B20: j) родительский штамм дикого типа B20, k) штамм B20-14 (зеленый), l) штамм B20-10 (лиловый), m) штамм B20-4 (альбинос/белый). Иллюстрация: npj Science of Food (2024). DOI: 10.1038/s41538-023-00244-9
